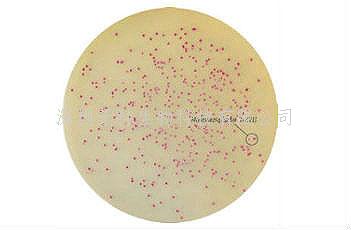
印度HiMedia 马拉色菌显色培养基

热门关键词: ELISA试剂盒 - 大鼠ELISA试剂盒- 小鼠ELISA试剂盒
全国统一客服热线:
0755-28715175
热门关键词: ELISA试剂盒 - 大鼠ELISA试剂盒- 小鼠ELISA试剂盒
全国统一客服热线:
0755-28715175

货品名称:印度 HiMedia 马拉色菌显色培养基
HiCrome Malassezia Agar (Twin Pack)
品牌:印度 HiMedia
货号:M1985
规格:15ml/46.4g/L
应用领域:临床-皮肤
应用:用于糠秕马拉色菌的分离、培养和鉴定
组分 g/L: Part A :特殊蛋白胨 30g/L; 显色混合物1.4g/L; 琼脂15g/L;Part B: 吐温40 10g/L; 甘油单油酸酯 5g/L
PH值:5.8±0.2
操作步骤:
1.取15ml Part B液体培养基置于1000ml去离子水的洁净三角瓶中。
2.再添加46.4g Part A脱水培养基。
3.缓慢加热,不停搅拌,使其完全溶解。将溶解完全的培养基高压灭菌(121ºC,15min)。
4.加热后的培养基冷却至45-50°C,倾注平皿,使其凝固,晾干备用。
接种:划线或涂布接种(冰箱内保存的平板使用前应恢复至室温)。
培养:在35-37℃下培养48-72小时。
结果:
微生物(Microorganisms) | 生长(Crescita) | 特征(Caratteristiche) |
糠秕马拉色菌 ATCC 14521 | 生长茂盛 | 紫色,菌落较小 |
白色念珠菌(10231) | 生长茂盛 | 绿色 |
光滑念珠菌(15126) | 生长茂盛 | 白色 |
克柔念珠菌(24408) | 生长茂盛 | 紫色 |
热带假丝酵母(750) | 生长茂盛 | 金属蓝 |
特性:
应用于:临床-皮肤样本
1.由于营养差异,一些菌落可能生长的比较小。
2.根据菌株的不同,可能会观察到轻微的颜色变化。
3.对于严重污染的样品,平板必须添加抑制剂,以抑制pH值较低的细菌生长。
贮存条件:干粉需保存于10-30ºC,制成的即用型平板应保存在2-8℃,在有效期前使用。
污染处理:
使用过的培养基需要在121ºC灭菌至少20分钟才可以按照有关规定丢弃。
附:供体外诊断使用,产品需专业人员操作。
0755-28715175/33164177

粤公网安备 44030902000304号